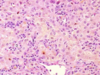

GI - Biliary Disease; Pancreatic Disease Flashcards
What does ERCP stand for in biliary tree examination?
Endoscopic retrograde cholangiopancreatography
__________ refers to impairment of bile flow (and resultant accumulation in hepatic parenchyma).
Cholestasis refers to impairment of bile flow (and resultant accumulation in hepatic parenchyma).
__________ refers to biliary tree infection.
Cholangitis refers to biliary tree infection.
__________ refers to gallstone formation in the biliary tree.
Choledocholithiasis refers to gallstone formation in the biliary tree.
RBC heme is converted to unconjugated bilirubin via what two enzymes?
Heme oxygenase
+
Biliverdin reductase
Bilirubin is hydro______ and carried to the liver by _________.
Bilirubin is hydrophobic and carried to the liver by albumin.
In the liver, bilirubin is conjugated with ___________ and secreted into bile (to enter the gut).
In the liver, bilirubin is conjugated with glucuronides and secreted into bile (to enter the gut).
This slide shows hepatic changes due to what form of cholestasis?

Mechanical obstruction
This slide shows hepatic changes due to what form of cholestasis?
Intrahepatic stasis
What non-acetominophen drug is especially associated with hepatic injury which potentially leads to intrahepatic cholestasis?
Amoxicillin - clavulinic acid
What severe genetic syndrome leads to an increase in serum unconjugated bilirubin?
What mild genetic syndrome leads to an increase in serum unconjugated bilirubin?
Crigler-Najjar syndrome
Gilbert’s syndrome
What severe genetic syndrome leads to an increase in serum conjugated bilirubin?
What mild genetic syndrome leads to an increase in serum conjugated bilirubin?
Dubin-Johnson syndrome
Rotor’s syndrome
Primary biliary cholangitis is most commonly seen in what demographic?
Middle-aged women
Primary biliary cholangitis is a(n) ___________ (etiology) disease most affecting the _______ (size or extent) biliary ducts.
Primary biliary cholangitis is an autoimmune disease most affecting the small biliary ducts.
What serum factors are elevated in cases of primary biliary cholangitis?
Anti-mitochondrial antibody
ALP
ANA
Bilirubin
ALT/AST
Cholesterol
Which is associated with xanthelasmas, primary biliary cholangitis or primary sclerosing cholangitis?
Primary biliary cholangitis
What are the three components of treatment for primary biliary cholangitis?
Ursodeoxycholic acid (a naturally-occurring bile acid),
alendronate (a bisphosphonate),
Ca2+
The diagnostic criteria for primary biliary cholangitis is 2/3 of the following:
1.
2.
3.
The diagnostic criteria for primary biliary cholangitis is 2/3 of the following:
- ANA-positive
- Cholestasis
- Suggestive liver biopsy
Primary biliary cholangitis most affects the ______hepatic ducts.
Primary biliary cholangitis most affects the intrahepatic ducts.
Describe the histological appearance of primary biliary cholangitis.
‘Jigsaw’ fibrosis;
granulomas surrounding hepatic portal ducts (extra-hepatic ducts normal)
Primary sclerosing cholangitis is most commonly seen in what demographic?
Middle-aged men
(2:1)
Primary sclerosing cholangitis is a(n) ___________ (etiology) disease most affecting the _______ (size or extent) biliary ducts.
Primary sclerosing cholangitis is an autoimmune disease most affecting the large biliary ducts.
What serum factors are elevated in cases of primary sclerosing cholangitis?
ALP
Bilirubin
(ANA-negative!)
Which is ANA-negative, primary biliary cholangitis or primary sclerosing cholangitis?
Primary sclerosing cholangitis
Which affects the intrahepatic ducts only, primary biliary cholangitis or primary sclerosing cholangitis?
Primary biliary cholangitis
Which can affect both the extrahepatic and intrahepatic ducts, primary biliary cholangitis or primary sclerosing cholangitis?
Primary sclerosing cholangitis
What are the S/Sy and features of primary sclerosing cholangitis?
Pruritus, fatigue, episodic jaundice, abdominal pain;
concomitant ulcerative colitis
Which is associated with ulcerative colitis, primary biliary cholangitis or primary sclerosing cholangitis?
Primary sclerosing cholangitis
How is primary sclerosing cholangitis diagnosed?
Liver biopsy + ERCP
(endoscopic retrograde cholangiopancreatography)
How will the biliary tree appear on ERCP in patients with primary sclerosing cholangitis?
‘Pearl necklace’ strictures;
onion skinning possible
What is the prognosis for primary sclerosing cholangitis?
It is progressive and incurable
Primary sclerosing cholangitis is associated with c___________, recurrent b_________, and g__________.
Primary sclerosing cholangitis is associated with cholangiocarcinoma, recurrent bacteremia, and gallstones.
What is the name for any biliary fibrosis / cirrhosis due to large duct trauma or extrahepatic obstruction by causes other than primary biliary sclerosis?
Secondary biliary sclerosis/cirrhosis
What is the term used to describe cysts of the biliary tree?
Choledochoceles
(choledochal cysts)
What is the term used to describe stone deposition in the gallbladder?
Cholelithiasis
A type ____ choledocholcele (a congeital biliary tree dilatation) protrudes into the duodenum.
A type III choledocholcele (a congeital biliary tree dilatation) protrudes into the duodenum.
What are some of the possible S/Sy of a choledochal cyst (choledocholcele)?
Abdominal pain,
jaundice,
palpable mass
Name the three most common infectious causes of cholangitis in descending order of occurrence.
Enterococci spp.
>
E. coli
>
Klebsiella spp.
Name a few etiologies of bile stasis that might lead to cholangitis.
Choledocholithiasis;
benign strictures;
malignancy;
choledochoceles
What are the three points of Charcot’s triad of cholangitis?
Fever, pain, jaundice
Reynaud’s pentad of cholangitis includes what two factors besides Charcot’s (fever, jaundice, and pain)?
Confusion,
hypotension
Describe the elevated serological features of cholangitis.
AST and ALT,
ALP,
bilirubin
How is cholangitis treated?
Ciprofloxacin
(or another fluoroquinolone)
Choledocholithiasis is more common in which gender?
Females
(2:1)
What are the four ‘F’s of choledocholithiasis?
Fat, fertile females over forty
Describe the gross appearance and character of cholesterol gallstones.
White, tough
Describe the gross appearance and character of pigment gallstones.
Black, crushable
How does choledocholithiasis typically present?
Asymptomatically
If asymptomatic, how does choledocholithiasis typically present?
Typically a sharp, colicky pain in RUQ or epigastric regions
(sometimes associated with fatty food intake)
A patient with cholecystitis presents with a positive Murphy’s sign. What happened when you compressed her gallbladder?
She stopped breathing
Name two fairly intense complications of choledocholithiasis.
Pancreatitis;
cholangitis
Do serum liver enzymes change with choledocholithiasis?
They can
(may be normal or abnormal)
How are gallstones typically diagnosed?
Ultrasound
or
ERCP
Gallbladder malignancies are ______ (frequency) and almost always ___________ (type).
Gallbladder malignancies are very rare and almost always adenocarcinomas.
Gallbladder malignancies are associated with chronic __________ and/or __________.
Gallbladder malignancies are associated with chronic inflammation and/or infection.
What infections are associated with development of gallstone malignancies?
- Helicobacter pylori*
- Salmonella typhi*
Which is more common, gallbladder malignancies or cholangiocarcinomas?
(I.e. which is more common, malignancies of the gallbladder or the biliary tree?)
Gallbladder malignancies
What is the term for an abberrant portion of pancreatic tissue found somewhere in the GI tract?
A pancreatic rest
True/False.
Pancreatic divisum (split pancreas) is fairly common and fairly benign.
True.
An annular pancreas can form via what process?
The natural rotation of the duodenum during development
Name two complications that an annular pancreas can cause.
Duodenal strictures;
pancreatitis
Name the two most common causes of pancreatitis and give the percentage of cases for which each is responsible.
Gallstones (40%);
alcohol (40%)
Autoimmune pancreatitis is associated with increased levels of serum _______.
Autoimmune pancreatitis is associated with increased levels of serum IgG4.
Pancreatitis is associated with _____calcemia.
Pancreatitis is associated with hypercalcemia (due to errant in-pancreas activation of pancreatic enzymes by calcium).
What is the main cause of ‘hereditary pancreatitis?’
Cystic fibrosis
What is the typical clinical presentation of pancreatitis?
Mid-epigastric pain through the back;
umbilical or back bruising may be present
What lab values are indicative of pancreatitis?
Elevated serum amylase and lipase
Name some of the many possible complications of pancreatitis.
Duodenal obstruction;
bile duct stricture;
gastric varices;
pseudoaneurysms
splenic rupture
What are the components of treating pancreatitis?
Rest the pancreas;
antacids + oral pill of pancreatic enzymes;
pain management
Why is it useful to treat pancreatitis with oral pills of pancreatic enzymes?
Subsequent downregulation of secretin and pancreatic enzyme secretion
Pancreatic cysts may be congenital.
Pancreatic pseudocysts are more associated with what processes?
Inflammation (pancreatitis) or neoplasia (e.g. serous or mucinous cystadenomas)
What is the most common sign of pancreatic malignancy?
Painless jaundice
Pancreatic malignancies are typically __________ (type) and present at a(n) _______-stage (early/mid/late).
Pancreatic malignancies are typically adenocarcinomas and present at a late-stage.